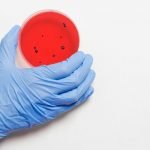
7 من أهم المعلومات عن البكتيريا والفيروسات

حياة مجتمع النحل
- ويعيش النحل حياة اجتماعية راقية رائعة التنظيم في مجتمعات يسمى الواحد منها خلية أو عش أو بيتاً، وتسكن هذا البيت الآلاف التي تنتمي لنوع الجماعة الواحدة نفسه وإن تنوعت أشكالها وتعددت وظائفها واختلفت أعمالها وتفاوتت أعمارها، فمنها العاملات والذكور والملكة الأم، وبين هؤلاء جميعا تعيش أطوار الذرية من بيض ويرقات وعذارى.
- فيصنع النحل بيته في جذوع الأشجار وفي ثقوب الجبال وفي أسقف بعض منازل الإنسان وتوجد في مسكن النحل مجموعة من الأقراص الشمعية يوازي بعضها البعض الآخر، ويتركب كل قرص من عيون سداسية الأضلاع، يتربى فيها البيض واليرقات والعذارى ويتم فيها تخزين العسل وحبوب اللقاح.
- وتوجد في كل خلية نحل ملكة واحدة، وظيفتها الأساسية هي وضع البيض، ومن وظائفها إشاعة الأمن والاستقرار في أرجاء الخلية، ولا تخرج الملكة من مملكتها إلا عند التلقيح والزواج، وإذا كبرت لا تخرج إلا على رأس طرد من النحل لبناء خلية جديدة، وإذا وضعته في العيون السداسية الصغيرة في الأقراص الشمعية، فإنه يفقس عن شغالات، أما البيض غير الملقح فإنه يفقس عن ذكور لا وظيفة لها إلا تلقيح الملكة أثناء طيران زفافها.
لغات التواصل عند النحل
لغة الرقص
فقد أكتشف العلماء أن المعلومة التي يوصلها النحل الكشاف من النحل السارح عن مصادر الرحيق وحبوب اللقاح و أتضح له أن النحلة السارحة الكشافة عندما تدخل خليتها تقوم بممارسة نوع خاص من الرقص يرتبط في طريقة أدائه مع بعد المصدر المكتشف والمكان الذي يوجد به.
الرقص الدائري
عندما يكون مصدر الغذاء قريب من الخلية بما لا يتعدى أل 50 متراً تقوم الشغالة المكتشفة لمصدر الغذاء عند دخولها الخلية بأداء الرقص الدائري، وفيه تتحرك فوق الأقراص داخل الخلية فى دوائر مع تغيير الإتجاه يمينا أو يسارا حسب الحالة وتستمر لعدة ثوانى ثم تنتقل لمكان أخر على القرص لتؤدى نفس الرقصة.
الرقص الاهتزازي
عندما يكون مصدر الغذاء ما بين 50 و 100 متراً أو أكثرتدخل الشغالة المكتشفة داخل الخلية لتقوم بالرقص الاهتزازى وفيه تستمر لمسافة قصيرة وفى خط مستقيم مع تحريك بطنها بسرعة من جانب لأخر.. ثم تتحرك فى قوس إلى اليسار ثم فى خط مستقيم ثانيا ثم تتحرك فى قوس إلى اليمين وتحدد المسافة بعدد اللفات التى تؤديها الشغالة فى وقت محدد فمثلا لو أن المسافة أكثر من 100 متر تقوم بدورات ما بين من 9 و 10 دورة فى مدة تقريبا 15 ثانية.
اللغة الكيماوية
وجد أن المادة الكيماوية التي تفرزها الملكة أو الشغالة لها مغزى خاص وتؤدى إلى سلوك معين فمثلا فهرمون الملكة الذي تفرزه الملكة تستقبله الشغالات والذكور لتنظيم العمل داخل الخلية وإتمام عملية التزاوج كما أن النحل الكشاف لمصدر الرحيق فى مكان ما تميزه لزميلاتها من نحل الطائفة بإفرازها لمادة ذات رائحة من غدد الرائحة فى بطنها ونشرها فوق مصدر الرحيق وفى المساحة التى تحيط بها حتى يستدل عليها بسهولة كما أنها تتبع ذلك عند عودتها لخليتها وهى محملة من رحيق المصدر المكتشف أو حبوب اللقاح.
لغة احداث الصوت
بالرغم من أن هذه اللغة بين أفراد الطائفة من التفاهم محدودة لكن فى بعض الأمور يلاحظ أن الملكات التى خرجت حديثا من البيوت الملكية تعمل اتصالاً عن طريق إحداث أصوات الصفير يشبه صوت البط والذي يسمع داخل أرضية وجدران الخلية لأن الملكات الصغيرة السن عندها المقدرة العالية للتعرف على بعضها البعض عن طريق الأصوات الخاصة وهذا الاتصال عن طريق الصفير بين الملكات خارج البيوت الملكية وداخلها ينظم عملية التطريد.
أقسام النحل وسلالاته
- تصنف فصيلة النحل الجامع للعسل في مجموعة من الأنواع المذكورة سابقاً، وينفرد نوع النحل العالمي للعسل وسلالاته البيئية بالانتشار العالمي ومن أهمهاالنحل السوري ، النحل القبرصي ، النحل التركي.
- ينتشر النحل الإيطالي في الأمريكتين الشمالية والجنوبية وأستراليا والنحل الكرنيولي في يوغسلافيا وأوربا، والنحل القوقازي في دول الاتحاد الروسي. تتقارب هذه السلالات في صفاتها العامة وتختلف أحياناً ألوانها وبعض الصفات الشكلية حسب البيئة التي تعيش فيها (باردة، دافئة أو مدارية).
منتجات النحل
الغذاء الملكي
تسكبه شغالات النحل الصغيرات السن في بيوت الملكات بنحو 250ـ 350 ملغ يومياً من دون توقف مدة 5ـ 6 أيام، وهو سائل ذو قيمة غذائية عالية يعطي الملكة ميزة الخصوبة العالية والطيران السريع يعمد النحّال إلى إدخال كؤوس شمعية أو لدائنية مشابهة للبيوت الملكية، يضع فيها من أقراص الحضنة الحديثة يرقات صغيرة في عمر يومين ثم يضع هذه الكؤوس مقلوبة في خلية نحل قوية بعد استبعاد ملكتها طائفة يتيمة مما يدفع النحل إلى تعويض ملكته فيغذي هذه اليرقات بغزارة. يستطيع المنتج سحب هذه المادة الغذائية الملكية بآلة شفط خاصة إلى وعاء صغير بعد تصفيته، ثم يضعه في البراد أو المجمِّدة إلى حين الاستعمال.
مادة اللسع
يخرج من أداة لسع شغالة نحل العسل مادة مهيجة تزرقها في جسم أعدائها حين إزعاجها داخل مساكنها أو بالقرب منها. ولهذه المادة أهمية في كشف حساسية الأشخاص للّسع حينما ينوون إنشاء مناحل بغرض الإنتاج الاقتصادي، كما تُستعمل طبياً لمعالجة الروماتيزم وبعض الأمراض العصبية في عيادات العلاج الطبيعي. ولجمع هذه المادة يُجبر النحل على دخول نفق ذي أرضية وبرية قطعة قماش من الصوف فتعلق أرجله بها فيتهيج ويلسع فتنزل قطرات اللسع إلى وعاء، ثم يُصفّى الناتج ويُجمع في أوعية صغيرة أو عبوات صغيرة تشبه إبر الأنسولين لإستعمالها طبياً.
مادة الشمع
هي إفراز طبيعي من غدد الشغالات المتوسطة العمر، تبني بها أقراصها وتربي حضنتها، وتعدّ هذه المادة عالية الجودة. ينصهر شمع النحل في درجة 60 ْ م ويلين في درجة 49 ْ م ويصبح حينئذ غير صالح لوضع الرحيق وتربية الحضنة brood.
أدوار جميع مجتمع النحل
جميع أفراد مجتمع الخلية سواء كانت الملكة الشغالات أو الذكور جميعهم يسعون لتحقيق نفس الهدف وهو ضمان بقاء الخلية وانتاجها لتحقيق هذا الهدف، يتم تقسيم أدوار نحل العسل بصورة واضحة كالتالى:
الملكة
تذهب في رحلتها للزواج بالذكور وتستهلك حوالى 10 ملايين من الحيوانات المنوية لاتمام عملية الاخصاب للمرة واحدة فقط. بعد ذلك، تضع ما يقرب من 2,000 بويضة مخصبة وغير مخصبة يوميا في خلايا الحضنة . وهذا يصل إلى 200,000 بيضة في الموسم الواحد. تخرج الشغالات من البويضات المخصبة، و الملكة الجديدة، أما الذكور فتخرج من البويضات غير المخصبة.
فضلاً عن وضع البيض تسيطر الملكة على كل ما يحدث في الخلية من خلال الفيرومونات. وهى مواد تدعم سلوك التعلم عند الشغالات، و تبقيهم معاً حتى وهم فى أسراب وتوقف تطور المبايض تكون ملكات جديدة، كما تجذب الذكور خلال موسم التكاثر.
كل عام تجهز الملكة الطريق لخليفتها. قبل أن تغادر الخلية في أوائل الصيف في سرب من آلاف النحل، تضع البيض فى خلايا ملكية معدة لهذا الغرض ويتم تربية ملكة جديدة السرب يستقر في مجموعات ضخمة، و يبحث عن منزل جديد الكثير من السعادة للنحالين حيث انهم يتمكنوا من جمع السرب من الشجرة وبالتالي امتلاك خلية نحل جديدة، ولكن هذا أيضاً يفيد للنحل، حيث أن نحل العسل لا يستطيع البقاء في البرية بدون منزل.
الشغالات
تشكل السواد الأعظم من سكان خلية النحل جهازها التناسلي غير متكامل وتتمتع بأجزاء فم طويلة لجمع الرحيق وأرجل خلفية لجمع حبوب اللقاح تعيش ما بين 1.5 – 5 أشهر، لكن دورة حياتها 21 يوماً ، على جسم الشغالة يوجد مجموعة من الغدد المُفرزة تساعدها هذه الغدد على فرز المادة السمية بعد اللسع وفرز الغذاء اللازم للحضنة وفرز أنزيم يحول السكريات الثنائية إلى سكريات أحادية وفرز رائحة خاصة بكل أفراد الطائفة وذلك لتمييز أفراد طائفتها وعدم دخول نحل غريب إلى الطائفة.
ولهذه الشريحة من النحل أساليب عجيبة ، فهي عندما تحس بتغير المكان مثلاً إذا نقل النحال خلايا النحل إلى مكان أخر بعيد عن مكان وجوده الأول، فان شريحة العاملات في هذه الخلية ترسل مجموعات من النحل للاستطلاع واكتشاف الأرض والمراعي الجديدة، وعند عودة نحل الاستطلاع هذا إلى خلية، فإنه يحاول إعطاء النحل في الخلية خارطة يحدد بموجبها موقع المراعى المستهدفة ، حيث يستعين في تحديد موقع المراعي بإتجاه الشمس ، و يتم التفاهم ما بين النحل عن طريق بعض الرقصات التي تعتبر من لغة النحل والتي يتم بموجبها إيصال الرسالة على أكمل وجه.
وإذا زاد عدد العاملات في الخلية بحيث أدى ذلك إلى ازدحام الخلية ، فإن النحل يلجأ إلى تربية ملكة جديدة ، وبعد نضوج الملكة الجديدة ترحل الملكة القديمة مع جماعات من الجيل الجديد من العاملات إلى مكان أخر، وبذلك تتكون خلية جديدة.
اليعسوب
تقضي ذكور النحل وقتاً صعباً فى مجتمع الخلية، و ليس فقط لأنها أقلية. بعد أن تخرج في فصل الربيع من البيض غير المخصب، تصبح المهمة الوحيدة للذكور في الحياة هي أن تخصب الملكة. تكون الأمور جيدة للذكور لعدة أيام فقط. ولكن في شهر مايو بمجرد أن تصبح الذكور التي بلا ذنب ناضجة جنسياً، تكون قد اقتربت النهاية. يتنافس الذكر مراراً وتكراراً مع الآلاف الذكور في ما يسمى بمناطق طيران التزاوج الجماعي ليتزاوج مع الملكة. إذا نجح في الوصول للملكة، فإنه يستخدم كل حيواناته المنوية ويموت. في الصيف، في نهاية سنة النحل تصبح الذكور المتبقية من عملية التلقيح معزولة اجتماعياً. وترفض الشغالات اعطائهم الغذاء ,ينفوا بعيدا وتمنع عودتهم إلى مجتمع الخلية مرة أخرى.
بواسطة: Amira Amin

اضف تعليق